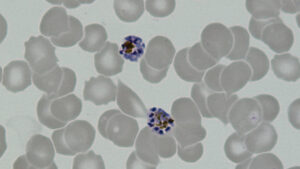

Periódico da UFSC publica edição dedicada aos dilemas informacionais e éticos na crise climática
A Universidade Federal de Santa Catarina (UFSC) publicou recentemente em um de seus periódicos uma edição dedicada aos dilemas informacionais e éticos em meio a